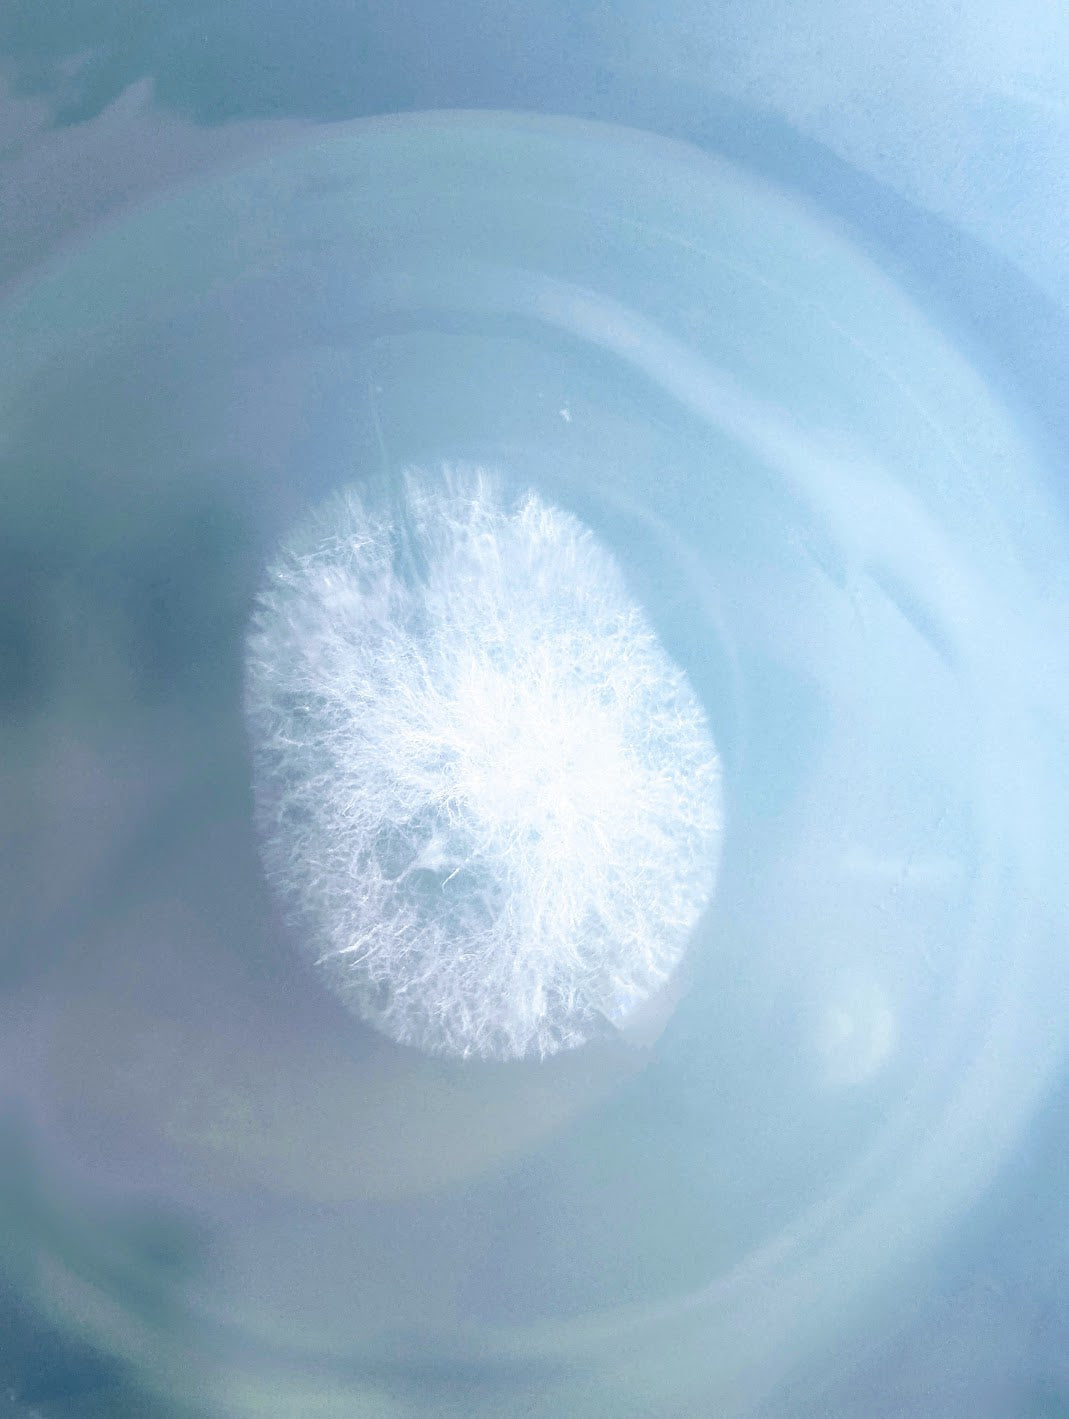
The Lancashire Enoki / Velvet Shank

The Lancashire Enoki / Velvet Shank
Share
In this blog I'll talk through how we're taking an exciting new specimen to culture at Moss Hill, with a sneak peak into the methods we use to take wild strains to possible cultivars in the lab.
Sometimes great things happen when you're not looking! In fact I was even't searching for mushrooms when I found this local Enoki specimen in Grainings Wood, Darwen.
We were out for a family walk, and I had my son Lenny strapped to me in his rucksack contraption. As we followed a bend in the trail, my eye was drawn to something poking from a tree ahead, a small flash of pale orange peeking from the mossy bark.

Grainings Wood is a pretty ramble, not too long and perfect for little legs, the path gently winding through dense growth of birch woodland. The wood is actually perched atop an old landfill, one of many similar council-owned sites you'll find up and down the country. I wouldn't forage mushrooms here to consume, although they certainly like to grow. Here I've seen Turkey Tail, Elf Cups, various Oysters, Oysterlings and lots of different bracket fungus, but never Enoki.
At the time I had no container I could take a sample with, and was wearing a small child on my back, making taking pictures and generally geeking in the direction of the mushroom difficult. I made a mental note of the tree and took a quick picture so I could return in a day or so.
And then of course... life didn't happen like that. This was January of this year, and a couple of days later we had the biggest freeze of the winter. Darwen was iced over and I duly forgot about the Enoki. It wasn't until around ten days later, after the frozen North had started to thaw, that our next family walk jogged my mind, and off we headed to the woods...

The same mushroom was still there, barely clinging to the tree! I for some reason did not take a picture at this point, despite this time being freed from the shackles of transporting a child.
In the time since our last visit the Enoki had of course frozen and thawed, with a lot of the cap now disintegrated. Taking what pieces remained, I headed home to put the small sections on foil and attempt to retrieve some spores.
I make spore prints like this pretty quick and dirty, as what you're working with is already teeming with all sorts of spores, bacteria and other particles. Just lay the pieces or mushroom cap on a piece of foil, or if possible suspend them above it using some cocktail sticks. Then cover this with a bowl. The spores should fall from the gills or pores of the mushroom over the next 24 hours or so.
After a couple of days there they were! A small patch of spores around the size of a five pence piece lay resting on the foil.

If there's one thing working with wild spores teaches you, its persistence. After working recently with another local specimen, the Darwen Oyster, we've felt all too well the pain of dirty agar dishes as time after time every attempt to cultivate the wild spores ends in contamination. What's key here is dilution - even the small square of foil I had would likely contain hundreds of thousands of spores, Enoki and otherwise - and so it is key to spread those spores out across a solution so that fewer will be present on the agar.
My particular method here is to autoclave a small mason jar containing a little water and a small stir bar. Once sterilised I open this in front of the flow hood and place the small piece of foil containing the spores inside. This jar is then closed and placed on the magnetic stirrer, tumbling the foil around inside the jar and shedding the spores away from the surface, spreading it throughout the solution. In the image below you'll see the foil to the left with the stir bar hiding behind somewhere. Notice how murky the water looks with spores.

To spread the spores on the agar I use an inoculation loop - a small tool with a handle one end, and a length of corkscrewed wire on the other, with the end of the wire formed into a tiny loop. This wire can be flame sterilised, and allows me to pick up a small drop of the solution at a time, which can then be spread across the sterile agar in front of the flow hood.
Once the spores are spread, it usually takes around a week to see any growth. I first saw activity along the side of one of the dishes! This actually was a blessing because it was away from the absolute mess on the agar itself, allowing for a much easier transfer.

When transferring from agar dishes, we take small pieces of clean looking mycelium and place them onto a new sterile dish. This allows us to see if any other unwanted contaminants are present within the culture as they'll usually appear on the surface of the new dish too. Providing your aseptic technique is good, you'll usually perform four or five of these transfers to give good confidence that you have a clean enough culture ready for expansion to liquid culture or spawn.

You can see we have nice clean growth with this latest transfer of the mycelium. This Enoki culture is looking good, and over the next few weeks and via a few more transfers we should hopefully be able to use it for some test blocks.
In our next blog, we'll be looking at how to expand our culture using various techniques, including grain spawn and liquid culture.
Until then happy hunting!
